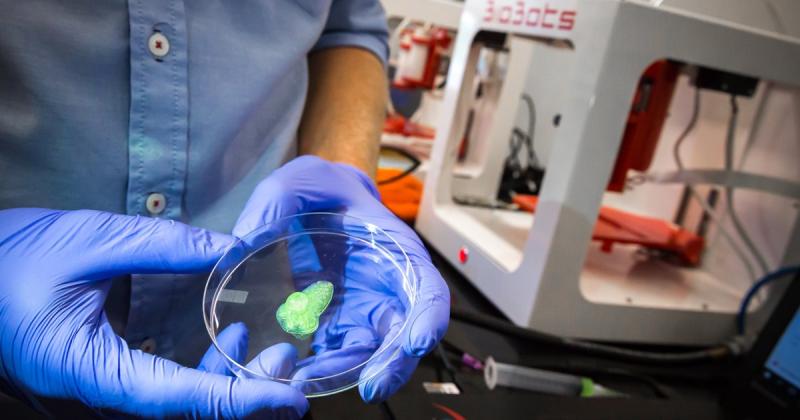

Press release
Tissue Transplantation Products and Services Market Generated Opportunities, Future Scope 2022-2028 | Abbott, Biomet, CryoLife, Inc., Arthrex, Exactech, Inc.
"๐๐ง๐๐ฎ๐ฌ๐ญ๐ซ๐ฒ ๐๐ง๐๐ฅ๐ฒ๐ฌ๐ข๐ฌ ๐ข๐ฌ ๐ ๐๐ซ๐ฎ๐๐ข๐๐ฅ ๐ฌ๐ญ๐๐ฉ ๐ข๐ง ๐ญ๐ก๐ ๐๐ฎ๐ซ๐ซ๐๐ง๐ญ ๐๐จ๐ฆ๐ฉ๐๐ญ๐ข๐ญ๐ข๐ฏ๐ ๐ฆ๐๐ซ๐ค๐๐ญ ๐ฌ๐ฉ๐๐๐ ๐ญ๐ก๐๐ญ ๐ก๐๐ฅ๐ฉ๐ฌ ๐ข๐๐๐ง๐ญ๐ข๐๐ฒ ๐ญ๐ก๐ ๐ซ๐ข๐ ๐ก๐ญ ๐ญ๐๐ซ๐ ๐๐ญ ๐๐ฎ๐ฌ๐ญ๐จ๐ฆ๐๐ซ๐ฌ ๐๐ง๐ ๐๐๐๐จ๐ซ๐๐ข๐ง๐ ๐ฅ๐ฒ ๐ฉ๐ซ๐จ๐ฏ๐ข๐๐ ๐ญ๐๐ข๐ฅ๐จ๐ซ๐๐ ๐ฌ๐จ๐ฅ๐ฎ๐ญ๐ข๐จ๐ง๐ฌ ๐๐จ๐ซ ๐ญ๐ก๐๐ข๐ซ ๐๐ฎ๐ฌ๐ข๐ง๐๐ฌ๐ฌ ๐ง๐๐๐๐ฌ. ๐๐ฏ๐๐ซ๐ฒ ๐๐ฌ๐ฉ๐๐๐ญ ๐๐ง๐ ๐ฎ๐ง๐ข๐ช๐ฎ๐ ๐๐ก๐๐ฅ๐ฅ๐๐ง๐ ๐๐ฌ ๐ฉ๐ฎ๐ญ ๐ฎ๐ฉ ๐๐ฒ ๐ญ๐ก๐ ๐ฉ๐๐ซ๐ญ๐ข๐๐ฎ๐ฅ๐๐ซ ๐ข๐ง๐๐ฎ๐ฌ๐ญ๐ซ๐ฒ ๐๐ซ๐ ๐๐๐ซ๐๐๐ฎ๐ฅ๐ฅ๐ฒ ๐ญ๐๐ค๐๐ง ๐ข๐ง๐ญ๐จ ๐๐จ๐ง๐ฌ๐ข๐๐๐ซ๐๐ญ๐ข๐จ๐ง ๐ฐ๐ก๐ข๐ฅ๐ ๐๐จ๐ซ๐ฆ๐ฎ๐ฅ๐๐ญ๐ข๐ง๐ ๐ญ๐ก๐๐ฌ๐ ๐ฌ๐จ๐ฅ๐ฎ๐ญ๐ข๐จ๐ง๐ฌ. ๐๐ญ ๐๐ฅ๐ฌ๐จ ๐ญ๐๐ค๐๐ฌ ๐ข๐ง๐ญ๐จ ๐๐จ๐ง๐ฌ๐ข๐๐๐ซ๐๐ญ๐ข๐จ๐ง ๐ฏ๐๐ซ๐ข๐จ๐ฎ๐ฌ ๐ ๐จ๐ฏ๐๐ซ๐ง๐ฆ๐๐ง๐ญ ๐ซ๐๐๐จ๐ซ๐ฆ๐ฌ, ๐๐จ๐ฆ๐ฉ๐๐ญ๐ข๐ญ๐ข๐ฏ๐ ๐๐ง๐ฏ๐ข๐ซ๐จ๐ง๐ฆ๐๐ง๐ญ, ๐๐ฎ๐ฌ๐ญ๐จ๐ฆ๐๐ซ ๐๐๐ก๐๐ฏ๐ข๐จ๐ซ, ๐๐ฑ๐ข๐ฌ๐ญ๐ข๐ง๐ ๐๐ง๐ ๐ฎ๐ฉ๐๐จ๐ฆ๐ข๐ง๐ ๐๐ฎ๐ฌ๐ข๐ง๐๐ฌ๐ฌ ๐ฆ๐จ๐๐๐ฅ๐ฌ, ๐๐ง๐ ๐๐ฏ๐๐ซ-๐๐ฏ๐จ๐ฅ๐ฏ๐ข๐ง๐ ๐ญ๐๐๐ก๐ง๐จ๐ฅ๐จ๐ ๐ข๐๐๐ฅ ๐๐๐ฏ๐๐ฅ๐จ๐ฉ๐ฆ๐๐ง๐ญ๐ฌ. ๐๐ง๐๐ฎ๐ฌ๐ญ๐ซ๐ฒ ๐๐ง๐๐ฅ๐ฒ๐ฌ๐ข๐ฌ ๐ก๐๐ฅ๐ฉ๐ฌ ๐๐ง ๐จ๐ซ๐ ๐๐ง๐ข๐ณ๐๐ญ๐ข๐จ๐ง ๐๐จ๐ซ๐ฆ๐ฎ๐ฅ๐๐ญ๐ ๐ฌ๐ญ๐ซ๐๐ญ๐๐ ๐ข๐๐ฌ ๐๐ง๐ ๐ฉ๐จ๐ฅ๐ข๐๐ข๐๐ฌ ๐จ๐ ๐ ๐๐ฎ๐ฌ๐ข๐ง๐๐ฌ๐ฌ."๐๐จ๐ก๐๐ซ๐๐ง๐ญ ๐๐๐ซ๐ค๐๐ญ ๐๐ง๐ฌ๐ข๐ ๐ก๐ญ๐ฌ released a new market study on 2022-2028 Tissue Transplantation Products and Services Market with 100+ market data Tables, Pie Chat, Graphs & Figures spread through Pages and easy to understand detailed analysis. The global research report delivers an in-depth watch on leading competitors with strategic analysis, small and macro business trends and eventualities, valuation analysis and a holistic summary within the forecast amount. Its knowledge and in-depth reports specializing in primary and secondary drivers, market share, leading segments, and geographical analysis. Further, key players, major collaborations, merger & acquisitions of trending innovation and business policies reviewed within the report. The report contains basic, secondary and advanced data referring to international standing and trend, size, share, growth, trends analysis, section, and forecasts.
The PDF for the study Request with this link: https://www.coherentmarketinsights.com/insight/request-pdf/76
๐๐๐ญ๐๐ข๐ฅ๐ข๐ง๐ ๐ญ๐ก๐ ๐๐ซ๐ฎ๐๐ข๐๐ฅ ๐ฉ๐จ๐ข๐ง๐ญ๐๐ซ๐ฌ ๐จ๐ฎ๐ญ๐ฅ๐ข๐ง๐๐ ๐ข๐ง ๐ญ๐ก๐ Tissue Transplantation Products and Services Market ๐ซ๐๐ฌ๐๐๐ซ๐๐ก ๐ซ๐๐ฉ๐จ๐ซ๐ญ:
The Market structure covers the value chain, player categories, product ranges, key players' presence across products and end user segments of the market. The report also provides a snapshot of key competition, market trends with forecast over the next 5-8 years, anticipated growth rates and the principal factors driving and impacting growth market data and analytics are derived from a combination of primary and secondary sources.
The research process involved the study of various factors affecting the industry, including the government policy, market situation, competitive landscape, historical data, present trends in the market, technological innovation, upcoming technologies and the technical progress in related industry, and market risks, opportunities, market barriers, and challenges.
๐ ๐ฌ๐ฒ๐ง๐จ๐ฉ๐ฌ๐ข๐ฌ ๐จ๐ ๐ญ๐ก๐ ๐ซ๐๐ ๐ข๐จ๐ง๐๐ฅ ๐ฅ๐๐ง๐๐ฌ๐๐๐ฉ๐ ๐จ๐ ๐ญ๐ก๐ ๐ฆ๐๐ซ๐ค๐๐ญ:
โ The research report broadly enumerates the regional terrain of this industry. As per the study, regional landscape is bifurcated into:
โ ๐๐จ๐ซ๐ญ๐ก ๐๐ฆ๐๐ซ๐ข๐๐: United States, Canada, and Mexico.
โ ๐๐จ๐ฎ๐ญ๐ก & ๐๐๐ง๐ญ๐ซ๐๐ฅ ๐๐ฆ๐๐ซ๐ข๐๐: Argentina, Chile, and Brazil.
โ ๐๐ข๐๐๐ฅ๐ ๐๐๐ฌ๐ญ & ๐๐๐ซ๐ข๐๐: Saudi Arabia, UAE, Turkey, Egypt, and South Africa.
โ ๐๐ฎ๐ซ๐จ๐ฉ๐: UK, France, Italy, Germany, Spain, and Russia.
โ ๐๐ฌ๐ข๐-๐๐๐๐ข๐๐ข๐: India, China, Japan, South Korea, Indonesia, Singapore, and Australia.
โ The study delivers substantial information pertaining to the market share that every region is estimated to hold, in tandem with the growth opportunities projected for each geography.
โ The report depicts the growth rate in which every topography is estimated to register over the forecast time period.
๐๐ง ๐จ๐ฎ๐ญ๐ฅ๐ข๐ง๐ ๐จ๐ ๐ญ๐ก๐ ๐๐จ๐ฆ๐ฉ๐๐ญ๐ข๐ญ๐ข๐ฏ๐ ๐ฅ๐๐ง๐๐ฌ๐๐๐ฉ๐ ๐จ๐ ๐ญ๐ก๐ ๐ฆ๐๐ซ๐ค๐๐ญ:
โฆฟ The comprehensive market report is inclusive of a detailed summary of the competitive analysis of this industry. As per the document, companies along the likes of Abbott, Biomet, CryoLife, Inc., Arthrex, Exactech, Inc., Celera, Folio Biosciences, Kรถhler Chemie, Bristol-Myers, LifeCell Corporation, Centacor and Novartis. are encompassed in the competitive spectrum of the market.
โฆฟ Data related production sites, market share, area served, and more have been covered in the report.
โฆฟ The report elucidates data pertaining to the manufacturer's product portfolio, product specifications, as well as numerous product applications.
โฆฟ A brief outline of the firm in question, its profit margins and pricing models are explained in the report as well.
Direct Purchase Report Here With Flat USD 2000 OFF @ https://www.coherentmarketinsights.com/promo/buynow/76
๐๐จ๐ฆ๐ ๐๐จ๐ข๐ง๐ญ๐ฌ ๐๐ซ๐จ๐ฆ ๐๐๐๐ฅ๐ ๐จ๐ ๐๐จ๐ง๐ญ๐๐ง๐ญ:
1. Overview and Scope
1.1. Research goal & scope
1.2. Research assumptions
1.3. Research methodology
1.3.1. Primary data sources
1.3.2. Secondary data sources
1.4. Key takeaway
1.5. Stakeholders
2. Executive Summary
2.1. Market definition
2.2. Market segmentation
3. Tissue Transplantation Products and Services Market Insights
3.1. Tissue Transplantation Products and Services - Industry snapshot
3.1.1. Leading Companies
3.1.2. Key Companies to Watch
3.2. Tissue Transplantation Products and Services - Ecosystem analysis
3.2.1. Market overview
3.2.2. Commercial Landscape
3.3. Tissue Transplantation Products and Services Market Dynamics
3.3.1. - Market Forces
3.3.1.1. Market Driver Analysis
3.3.1.2. Market Restraint/Challenges analysis
3.3.1.3. Market Opportunity Analysis
3.4. Industry analysis - Porter's five forces
3.4.1. Bargaining power of supplier
3.4.2. Bargaining power of the buyer
3.4.3. Threat of substitute
3.4.4. The threat of new entrant
3.4.5. Degree of competition
3.5. Market PEST Analysis
3.6. Market Value Chain Analysis
3.7. Industry Trends
3.8. Competitive Ranking Analysis
๐๐จ๐ง๐ญ๐ข๐ง๐ฎ๐๐โฆโฆโฆโฆ..
๐๐จ๐ง๐ญ๐๐๐ญ ๐๐ฌ
Mr. Shah
Coherent Market Insights
1001 4th Ave, #3200
Seattle, WA 98154
Phone: US +12067016702 / UK +4402081334027
Email: sales@coherentmarketinsights.com
๐๐๐จ๐ฎ๐ญ ๐๐จ๐ก๐๐ซ๐๐ง๐ญ ๐๐๐ซ๐ค๐๐ญ ๐๐ง๐ฌ๐ข๐ ๐ก๐ญ๐ฌ:
Coherent Market Insights is a prominent market research and consulting firm offering action-ready syndicated research reports, custom market analysis, consulting services, and competitive analysis through various recommendations related to emerging market trends, technologies, and potential absolute dollar opportunity.
This release was published on openPR.
Permanent link to this press release:
Copy
Please set a link in the press area of your homepage to this press release on openPR. openPR disclaims liability for any content contained in this release.
You can edit or delete your press release Tissue Transplantation Products and Services Market Generated Opportunities, Future Scope 2022-2028 | Abbott, Biomet, CryoLife, Inc., Arthrex, Exactech, Inc. here
News-ID: 2614632 • Views: โฆ
More Releases from Coherent Market Insights
Blood Plasma Market Booming with Rapid Growth Through 2033 |CSL Behring, Grifols โฆ
The latest report by Coherent Market Insights indicates strong growth potential for the Blood Plasma Market from 2026 to 2033, supported by rising industry demand, expanding applications, and ongoing technological advancements. The study delivers a clear overview of market size, revenue trends, and key growth factors shaping the global landscape. This research analyzes major market drivers, restraints, challenges, and emerging opportunities, while highlighting innovation trends and financial insights influencing competitiveโฆ
Ginger Beer Market Growth in Future Scope 2026-2033 |Fever-Tree, Crabbie's Ginge โฆ
The Global Business Landscape is being reshaped by rapid innovation, rising investment and shifting regional dynamics - and at the heart of this transformation lies the Ginger Beer Market. From 2026 to 2033, this study delivers key insights, clear segmentation and actionable intelligence to help decision-makers navigate the evolving Ginger Beer Market and capitalise on upcoming opportunities.
Report Highlights
โข Strategic coverage of investment hotspots, regional trend shifts and emerging segments.
โข Deepโฆ
Bortezomib Market In-depth Insights, Business Opportunities and Top Companies An โฆ
The latest report by Coherent Market Insights indicates strong growth potential for the Bortezomib Market from 2026 to 2033, supported by rising industry demand, expanding applications, and ongoing technological advancements. The study delivers a clear overview of market size, revenue trends, and key growth factors shaping the global landscape. This research analyzes major market drivers, restraints, challenges, and emerging opportunities, while highlighting innovation trends and financial insights influencing competitive strategies.โฆ
GCC Outbound Tourism Market See Incredible Growth 2026-2033 |Al Futtaim Travel, โฆ
The Global Business Landscape is being reshaped by rapid innovation, rising investment and shifting regional dynamics - and at the heart of this transformation lies the GCC Outbound Tourism Market. From 2026 to 2033, this study delivers key insights, clear segmentation and actionable intelligence to help decision-makers navigate the evolving GCC Outbound Tourism Market and capitalise on upcoming opportunities.
Report Highlights
โข Strategic coverage of investment hotspots, regional trend shifts and emergingโฆ
More Releases for Tissue
Tissue Paper Market: Unraveling the Sustainability and Versatility of Tissue Pro โฆ
Exploring the Mysteries of the Tissue Paper Market: A Comprehensive Market Research Report
Discover the intricate tapestry of the "Tissue Paper Market" through our latest market intelligence opus. This comprehensive report delves deep into the heart of this mystical realm, offering an immersive journey through descriptive data and insightful visuals that illuminate both local nuances and global trends. Uncover the essence of leading competitors, their market value treasures, evolving strategies,โฆ
Tissue Towel Market Report 2021: COVID-19 Growth And Change Players are Cascades โฆ
The Tissue Towel Market is rising at a sooner tempo with considerable development charges over the previous couple of years and is estimated that the market will develop considerably within the forecasted period.
Looking for More Insights from this Report? Get Free Sample Copy @ https://www.databridgemarketresearch.com/request-a-sample/?dbmr=north-america-tissue-towel-market&utm_source=manisha
(The sample of this report is readily available on request)
This Free report sample includes:
โข A brief introduction to the research report.
โข Graphical introduction of the regionalโฆ
Printed Tissue Paper Market 2020 Strategic Assessment - Royal Tissue Products., โฆ
Printed Tissue Paper Marketย In-depth Analysis 2020-2027
The Printed Tissue Paperย Market provides a 360 view and insights, outlining the key outcomes of the industry, current scenario witnesses a slowdown and study aims to unique strategies followed by key players. The research is derived through primary and secondary statistics sources and it comprises both qualitative and quantitative detailing. The study bridges the historical data from 2014 to 2020 and estimated till 2027*. Someโฆ
Industry Update: Printed Tissue Paper Market Set New Growth Story | Royal Tissue โฆ
Printed Tissue Paper Market will reach an estimated valuation of USD 651.2 million by 2027, while registering this growth at a rate of 4.80% for the forecast period of 2020 to 2027. FMCG Industry is facing Challenges to adapt to new Delivery and Purchasing Pattern to Ride out the Covid19 Disruption
Increasing knowledge concerning sanitation and healthcare is a principal constituent stimulating the market for tissue paper. Furthermore, practice of tissueโฆ
Roll Towel Tissue Towel Market 2018 Organized Authoritative Study report By WEPA โฆ
Fior Markets offers a latest published report on Global Roll Towel Tissue Towel Market Growth 2018-2023, providing key insights and giving a competitive advantage to consumers through a detailed report. The researchers have included essential figures associated with the production and consumption forecast for the major regions that the market is separated into consumption forecast by application and production forecast by type. The research study is a source of methodicalโฆ
Tissue Expanders Market Global Review 2017 to 2026| by Region - North America, L โฆ
According to Fact.MR, the global tissue expanders market is expected to represent a value of over US$ 800 Mn by the end of 2026.
Removal of breast attributed to growing cases of breast cancer has led to surge in demand for reconstructing breast. In addition, increasing demand for reconstructing the scalp and forehead skin attributed to skin distinction is expected to contribute towards growth of the global tissue expanders market duringโฆ